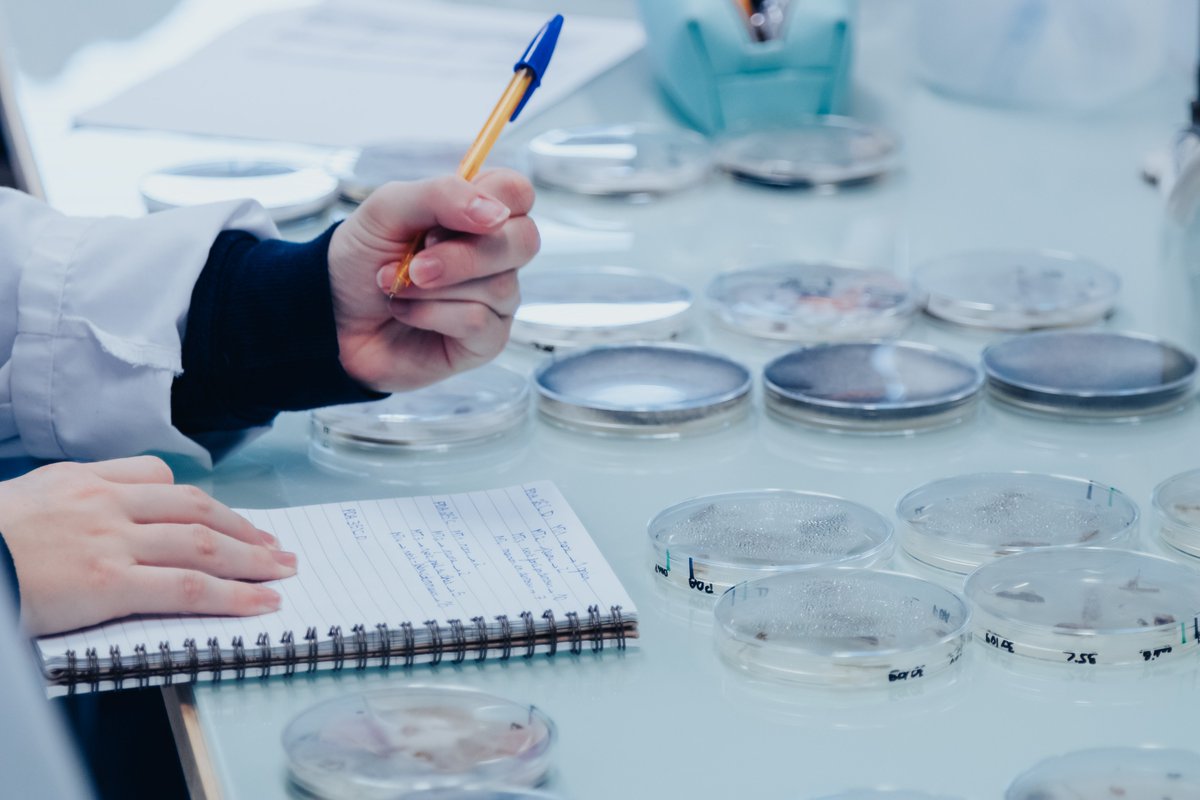
🚨 Avis aux futurs ingénieurs/BUT2, dernière ligne droite pour les inscriptions à l' ESIAB pour la rentrée prochaine: 🚀 30 mai 2023. 

- Ingénieur ᴍɪᴄʀᴏʙɪᴏʟᴏɢɪᴇ ᴇᴛ ǫᴜᴀʟɪᴛᴇ
- Ingénieur ᴀɢʀᴏᴀʟɪᴍᴇɴᴛᴀɪʀᴇ à Quimper 

<a href="/ESIABatlantique/">ESIAB</a> <a href="/UBO_UnivBrest/">UBO - Univ. Brest</a>

ESIAB
@esiabatlantique
École Supérieure d'Ingénieurs en Agroalimentaire de Bretagne atlantique. École interne @UBO_UnivBrest
ID: 1285839212
https://www.univ-brest.fr/esiab/ 21-03-2013 12:19:26
559 Tweet
326 Followers
341 Following

Assemblée Générale du Technopôle. Ouverture par Michel Gourtay, Président, et Gaétan Le Floch ESIAB Campus mondial de la mer French Tech Brest Bretagne Ouest Merci à tous les participants






Les chercheur·e·s de l'UBO vous donnent rendez-vous pour la Nuit Européenne des Chercheurs à Océanopolis Brest le vendredi 29 septembre... 2123 ! Venez rencontrer des scientifiques passionné·e·s sur les 15 stations avec les scientifiques de l'UBO pour découvrir la recherche du futur 👨🔬👩🔬


👩🏽🔬 👨🏽🔬 Poursuite de l'opération de science participative, menée dans le cadre du ᴘʀᴏᴊᴇᴛ ᴅᴇ ʀᴇᴄʜᴇʀᴄʜᴇ ᴍʏɴɪᴏɴ (MYcotoxiN migratION) de collecte de moisissures alimentaires. letelegramme.fr/bretagne/a-lub… #LUBEM, @ESIAB #RechercheUBO #radio #presse Lab EcoGestion Ouest Monika Coton





🥇 1er prix d'excellence des thèses du domaine Santé-Agro-Matières 2023 pour Marie Belair, sur le sujet : Les agents du dépérissement des noyers en France : écologie, diversité et cycle de vie. Thèse réalisée au LUBEM ! UBO - Univ. Brest Bravo !


Nouvelle vie aux déchets plastiques de labos de recherche portée par l' @UBO_OpenFactory, UBO - Univ. Brest, LUBEM ouest-france.fr/societe/lubo-d…

📣[Conférence: micro-plastiques ] L'impact sur la chaine trophique, la composition et la dynamique de colonisation de la planisphère, les actions menées par LUBEM dans le cadre du projet Recycl'Lab ! 👉 RDV le 12 avril au PNBI ou le 15 à Quimper ! UBO - Univ. Brest
![ESIAB (@esiabatlantique) on Twitter photo 📣[Conférence: micro-plastiques ]
L'impact sur la chaine trophique, la composition et la dynamique de colonisation de la planisphère, les actions menées par LUBEM dans le cadre du projet Recycl'Lab ! 👉 RDV le 12 avril au PNBI ou le 15 à Quimper ! <a href="/UBO_UnivBrest/">UBO - Univ. Brest</a> 📣[Conférence: micro-plastiques ]
L'impact sur la chaine trophique, la composition et la dynamique de colonisation de la planisphère, les actions menées par LUBEM dans le cadre du projet Recycl'Lab ! 👉 RDV le 12 avril au PNBI ou le 15 à Quimper ! <a href="/UBO_UnivBrest/">UBO - Univ. Brest</a>](https://pbs.twimg.com/media/GJv-TyZXMAEi2oG.jpg)




Participation de LUBEM à la Nuit européenne des chercheurs 🌙 ce vendredi 27 sept à Océanopolis Brest !


👉 𝗟𝗨𝗕𝗘𝗠 (Laboratoire Universitaire de Biodiversité et d'Ecologie Microbienne) sera présent au Village de la Science Brest pour présenter ses thématiques de recherche sur les champignons 🍄 et 𝐜𝐡𝐚𝐦𝐩𝐢𝐠𝐧𝐨𝐧𝐬 𝐦𝐚𝐫𝐢𝐧𝐬 ! 🪸🌱 Océanopolis Brest

![ESIAB (@esiabatlantique) on Twitter photo 🏆esiab [ 3ème Prix - Concours International de cuisine]
Clémentine Hong, Angèle Gueguen et Léa Bellot sont lauréates du XIème concours international de cuisine note à note sur le thème du ɢᴀsᴘɪʟʟᴀɢᴇ ᴀʟɪᴍᴇɴᴛᴀɪʀᴇ.
<a href="/ESIABatlantique/">ESIAB</a> , <a href="/UBO_UnivBrest/">UBO - Univ. Brest</a> , @UBO_OpenFactory 🏆esiab [ 3ème Prix - Concours International de cuisine]
Clémentine Hong, Angèle Gueguen et Léa Bellot sont lauréates du XIème concours international de cuisine note à note sur le thème du ɢᴀsᴘɪʟʟᴀɢᴇ ᴀʟɪᴍᴇɴᴛᴀɪʀᴇ.
<a href="/ESIABatlantique/">ESIAB</a> , <a href="/UBO_UnivBrest/">UBO - Univ. Brest</a> , @UBO_OpenFactory](https://pbs.twimg.com/media/F7CR2nVXUAEyinS.jpg)

